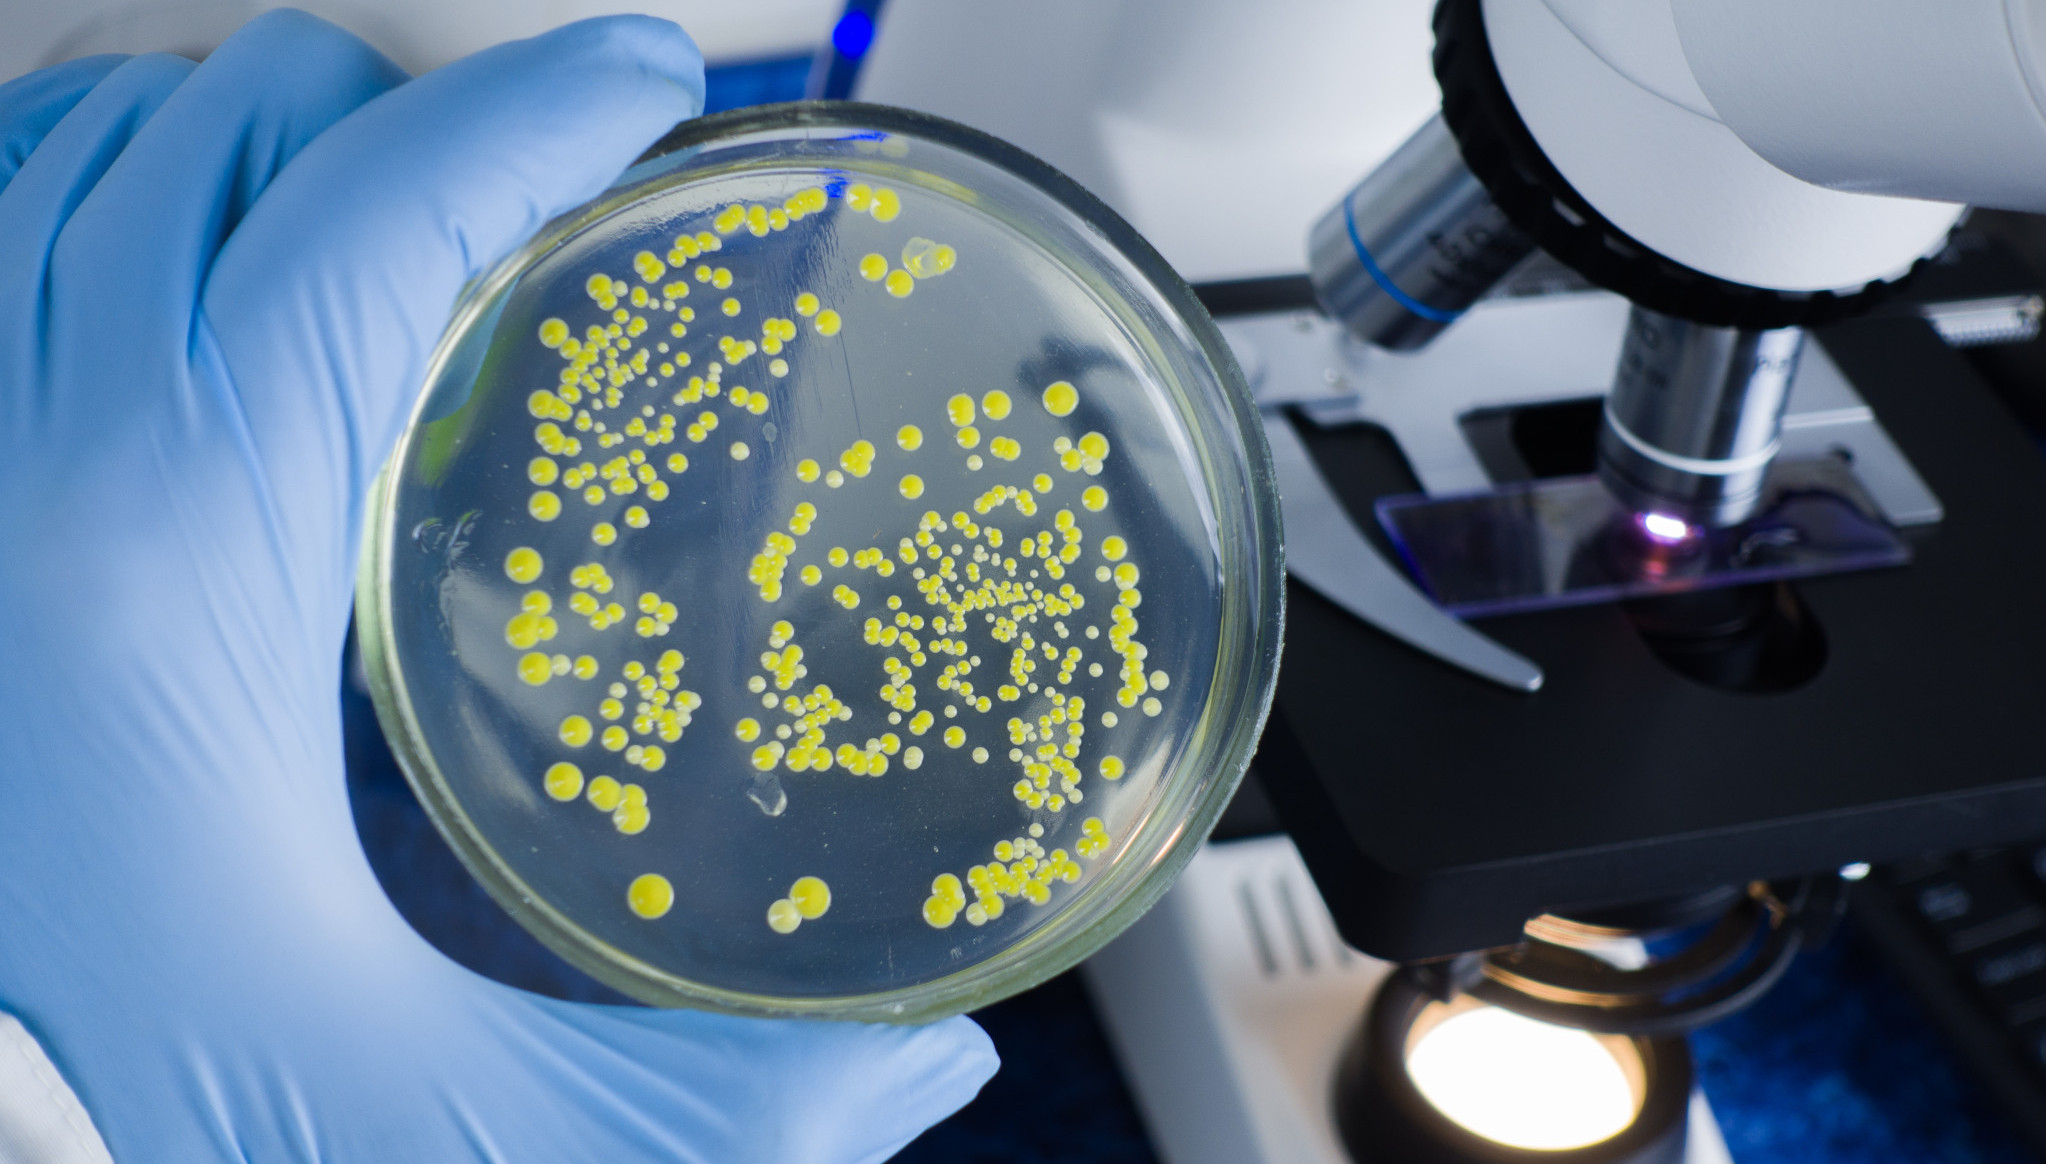

Sigurno ste i vi čuli za takozvano pravilo "pet sekundi", prema kojem, ukoliko u tom vremenskom periodu podignete sa poda nešto što vam je ispalo od hrane, slobodno možete i da ga pojedete. Ovo pravilo se oslanja na to da se štetne materije, bakterije i slično neće preneti u nekoj većoj količini, pa da je iz tog razloga sasvim u redu da pojedete to što vam je ispalo.
Jedna stranica na društvenoj mreži TikTok posvećena je istraživanju koliko su neke stvari zapravo prljave, pa je uradila eksperiment, kako bi potvrdila, odnosno opovrgla teoriju "5 sekundi".
U eksperimentu je određeno vreme od 0, 5, 10, 20, 30 sekundi i jedan minut, a rezultati su mnoge iznenadili.
Ispostavilo se da nema velike razlike između prenesenih bakterija tokom 5 sekundi i celog minuta, a kako je to izgledalo, pogledajte u snimku: